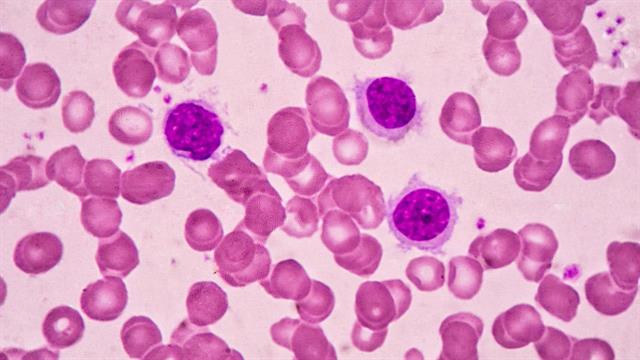
Τι ανακοινώθηκε στο 3ο Συνέδριο της Εταιρείας Μελέτης της Βιολογίας και Θεραπείας του Καρκίνου

Η Παγκόσμια Ημέρα Σπάνιων Παθήσεων καθιερώθηκε το 2008 από τον Ευρωπαϊκό Οργανισμό Σπανίων Παθήσεων (EURORDIS) και τιμάται έκτοτε την τελευταία ημέρα του Φεβρουαρίου (28/2), με σκοπό την ευαισθητοποίηση του κοινού και την ενίσχυση του συστήματος υγείας σχετικά με τους πάσχοντες από σπάνιο νόσημα, την πρόληψη και τη θεραπεία τους. Κύριος στόχος είναι η άμεση πρόσβαση των ασθενών με σπάνιες παθήσεις στην ολιστική φροντίδα υγείας και η βελτίωση της ποιότητας ζωής τους. Η βελτίωση στην παροχή υγειονομικής φροντίδας για τις Σπάνιες Παθήσεις αποτελεί μία μεγάλη πρόκληση λόγω της σχετικής έλλειψης επιδημιολογικών και επιστημονικών δεδομένων.
Ένα νόσημα θεωρείται σπάνιο όταν προσβάλει 5 στα 10.000 άτομα στο γενικό πληθυσμό και περισσότερες από 8.000 νόσοι έχουν καταγραφεί έως σήμερα ως σπάνιες. Υπολογίζεται ότι περίπου 10% του γενικού πληθυσμού θα προσβληθεί κάποια στιγμή κατά τη διάρκεια της ζωής του. Δηλαδή, περίπου 30 εκατομμύρια άνθρωποι στην Ευρωπαϊκή ένωση και περίπου 1 εκατομμύριο Έλληνες προσβάλλονται ή πρόκειται να προσβληθούν από μια σπάνια ασθένεια.
Απαιτείται συνεργασία πολλών ειδικοτήτων και μόνο με διεπιστημονική προσέγγιση μπορεί να διαγνωστούν και αντιμετωπιστούν έγκαιρα. Τα Κέντρα Εμπειρογνωμοσύνης Σπανίων Νοσημάτων διαθέτουν εξειδικευμένες γνώσεις για τη διάγνωση, την περίθαλψη, την παρακολούθηση και τη διαχείριση αυτών των ασθενών. Διαθέτουν τον απαραίτητο εξοπλισμό, παρέχουν υψηλό επίπεδο υπηρεσιών υγείας, διαμορφώνουν τις κατευθυντήριες οδηγίες και συμβάλλουν στην προώθηση της έρευνας, διασφαλίζοντας ότι η παρεχόμενη περίθαλψη έχει ως επίκεντρο τον ασθενή. Συνεργάζονται συστηματικά με τους συλλόγους των ασθενών, αλλά και με άλλα κέντρα και δίκτυα σε εθνικό και σε ευρωπαϊκό επίπεδο.
Στο πλαίσιο της ενασχόλησης με τις Σπάνιες Παθήσεις, ολοκληρώθηκαν με επιτυχία οι εργασίες του 3ου Πανελληνίου Συνεδρίου της Ιατρικής Εταιρείας Μελέτης της Βιολογίας και Θεραπείας του Καρκίνου (Ι.Ε.Μ.ΒΙ.ΘΕ.Κ.), που πραγματοποιήθηκε στις 21-23 Φεβρουαρίου 2025 στην Αθήνα.
Το συνέδριο, το οποίο διοργανώθηκε σε συνεργασία με τη Μονάδα Πλασματοκυτταρικών Δυσκρασιών και το Κέντρο Εμπειρογνωμοσύνης στην Αμυλοείδωση της Θεραπευτικής Κλινικής της Ιατρικής Σχολής του ΕΚΠΑ (Διευθυντής: Καθηγητής Θάνος Δημόπουλος, τ. Πρύτανης ΕΚΠΑ), είχε ως κεντρικό θέμα:
«Αμυλοείδωση και άλλα Σπάνια Αιματολογικά Νεοπλάσματα: Προσεγγίσεις στη Διάγνωση και τη Θεραπεία». Κατά τη διάρκεια των 3 ημερών, 234 άτομα με φυσική παρουσία και 230 άτομα εξ’ αποστάσεως παρακολούθησαν τις εργασίες του συνεδρίου.
Σκοπός του συνεδρίου ήταν η παρουσίαση των τελευταίων επιστημονικών εξελίξεων στη διάγνωση, την πρόγνωση και τη θεραπεία της αμυλοείδωσης και των σπάνιων αιματολογικών νεοπλασιών. Μέσα από στρογγυλά τραπέζια, διαλέξεις και επιστημονικές συζητήσεις, επιδιώχθηκε η ενίσχυση της γνώσης και η βελτίωση της κλινικής πρακτικής στον συγκεκριμένο τομέα.
Καταξιωμένοι επιστήμονες από την Ελλάδα και το εξωτερικό, όπως η Καθηγήτρια Καρδιολογίας Marianna Fontana από το Εθνικό Κέντρο Αμυλοείδωσης University College London του Ηνωμένου Βασιλείου και ο Καθηγητής Αιματολογίας – Ογκολογίας Saad Usmani από το Memorial Sloan Kettering Cancer Center των ΗΠΑ, συμμετείχαν στις εργασίες του συνεδρίου, ανταλλάσσοντας απόψεις και γνώσεις πάνω στις νεότερες θεραπευτικές στρατηγικές και τις τεχνολογικές εξελίξεις στη διάγνωση και διαχείριση των εν λόγω νοσημάτων.
Η πρώτη ημέρα ξεκίνησε με τον χαιρετισμό του προέδρου του συνεδρίου, Καθηγητή Ευάγγελου Τέρπου, και του Διευθυντή της Θεραπευτικής Κλινικής, Καθηγητή Θάνου Δημόπουλου, και ακολούθησαν συνεδρίες αφιερωμένες στα σπάνια λεμφοκυτταρικά νεοπλάσματα των Β- και Τ-κυττάρων, όπως τα επιθετικά Β-λεμφώματα με ειδικές μοριακές βλάβες, τα double-hit λεμφώματα, το αγγειοανοσοβλαστικό Τ-λέμφωμα ή το ηπατοσπληνικό λέμφωμα. Ιδιαίτερη έμφαση δόθηκε σε σπάνια αιματολογικά νοσήματα όπως η μαστοκυττάρωση, η ιδιοπαθής πολυκεντρική νόσος του Castleman, η ιστιοκυττάρωση Langerhans και σπάνια μυελοϋπερπλαστικά νεοπλάσματα, όπου συζητήθηκαν καινοτόμες θεραπευτικές προσεγγίσεις που στοχεύουν στη βελτίωση της επιβίωσης και της ποιότητας ζωής των ασθενών με τα νοσήματα αυτά.
Η δεύτερη ημέρα ήταν αφιερωμένη στην αμυλοείδωση, με θεματικές που κάλυψαν από τη βασική και μεταφραστική έρευνα έως την κλινική αντιμετώπιση της νόσου. Κορυφαίοι ερευνητές και κλινικοί ιατροί συζήτησαν για τις νέες θεραπευτικές επιλογές στην καρδιακή αμυλοείδωση υπό τον συντονισμό του Επιστημονικού Υπεύθυνου για το Κέντρο Εμπειρογνωμοσύνης στην Αμυλοείδωση στη Θεραπευτική Κλινική ΕΚΠΑ, Καθηγητή Ευστάθιου Καστρίτη, ενώ ιδιαίτερο ενδιαφέρον προσέλκυσε η ενότητα για τη χρήση της τεχνητής νοημοσύνης στην έγκαιρη διάγνωση.
Η τελευταία ημέρα του συνεδρίου εστίασε στις πλασματοκυτταρικές δυσκρασίες και τις επιπλοκές τους, με έμφαση στις νέες προσεγγίσεις για τη διάγνωση, ταξινόμηση, και θεραπεία της μονοκλωνικής γαμμαπάθειας κλινικής σημασίας. Οι εργασίες ολοκληρώθηκαν με τη θεματική ενότητα για τη μακροσφαιριναιμίας Waldenström, που συντόνισε η Αναπληρώτρια Καθηγήτρια Θεραπευτικής – Ογκολογίας Μαρία Γαβριατοπούλου και ο Καθηγητής Ευστάθιος Καστρίτης, όπου συζητήθηκαν οι γενετικές αλλαγές της νόσου, οι νέες θεραπευτικές επιλογές στην πρώτη γραμμή θεραπείας και στην υποτροπή, καθώς και οι σπανιότερες επιπλοκές της νόσου.
Το 3ο Πανελλήνιο Συνέδριο Ι.Ε.Μ.ΒΙ.ΘΕ.Κ. αποτέλεσε ένα σημαντικό επιστημονικό γεγονός, φέρνοντας στο προσκήνιο τα τελευταία ερευνητικά και θεραπευτικά δεδομένα για την αμυλοείδωση και τα σπάνια αιματολογικά νεοπλάσματα. Η ανταλλαγή γνώσεων και εμπειριών μεταξύ ειδικών, αλλά και η παρουσίαση νέων ερευνητικών ευρημάτων, επιβεβαίωσε τη σημασία της διεπιστημονικής συνεργασίας στο πλαίσιο λειτουργίας εξειδικευμένων κέντρων για τη βελτίωση της διάγνωσης και της θεραπείας αυτών των σύνθετων νοσημάτων.
Πηγές:
ΕΚΠΑ
Ειδήσεις υγείας σήμερα
Ποιοι παράγοντες επηρεάζουν το πόσες θερμίδες καίμε
Κ. Γιαννακόπουλος: Έβδομη θητεία για τον μακροβιότερο πρόεδρο Ιατρικού Συλλόγου
Υπουργείο Κοινωνικής Συνοχής: Μονιμοποιείται ο θεσμός του προσωπικού βοηθού [νομοσχέδιο]
Νέα εξέταση αίματος εντοπίζει περισσότερα περιστατικά επιθετικού καρκίνου στον προστάτη [μελέτη]
Νέα εξέταση αίματος εντοπίζει περισσότερα περιστατικά επιθετικού καρκίνου στον προστάτη [μελέτη] Το διεθνές Forum της ΕΛΛΟΚ για τον καρκίνο διοργανώνεται στην Αθήνα για τρίτη συνεχή χρονιά
Το διεθνές Forum της ΕΛΛΟΚ για τον καρκίνο διοργανώνεται στην Αθήνα για τρίτη συνεχή χρονιά Nέα ελπιδοφόρα επιλογή για την αντιμετώπιση της κόπωσης σε ασθενείς με καρκίνο
Nέα ελπιδοφόρα επιλογή για την αντιμετώπιση της κόπωσης σε ασθενείς με καρκίνο Καρκίνος παχέος εντέρου και ορθού: Η πρόληψη σώζει ζωές
Καρκίνος παχέος εντέρου και ορθού: Η πρόληψη σώζει ζωές Δ. Σαρηγιάννης: Εκτίμηση διακινδύνευσης για καρκίνο με βάση το εκθεσίωμα
Δ. Σαρηγιάννης: Εκτίμηση διακινδύνευσης για καρκίνο με βάση το εκθεσίωμα Choice Project - Breast Cancer Literacy του Αριστοτέλειου Πανεπιστημίου Θεσσαλονίκης
Choice Project - Breast Cancer Literacy του Αριστοτέλειου Πανεπιστημίου Θεσσαλονίκης Ποιοι παράγοντες επηρεάζουν το πόσες θερμίδες καίμε
Ποιοι παράγοντες επηρεάζουν το πόσες θερμίδες καίμε Κ. Γιαννακόπουλος: Έβδομη θητεία για τον μακροβιότερο πρόεδρο Ιατρικού Συλλόγου
Κ. Γιαννακόπουλος: Έβδομη θητεία για τον μακροβιότερο πρόεδρο Ιατρικού Συλλόγου Είναι κακό που το παιδί μου πιπιλάει τον αντίχειρά του;
Είναι κακό που το παιδί μου πιπιλάει τον αντίχειρά του; ECDC: Πέντε άτομα σε στενή επαφή με τον Γάλλο γιατρό που μολύνθηκε από Έμπολα
ECDC: Πέντε άτομα σε στενή επαφή με τον Γάλλο γιατρό που μολύνθηκε από Έμπολα Στατίνες: Προκαλούν σοβαρά μυϊκά προβλήματα;
Στατίνες: Προκαλούν σοβαρά μυϊκά προβλήματα; Με ποιες τροφές να συνδυάζω ρύζι, πατάτες και ζυμαρικά για να μην αυξάνεται απότομα το σάκχαρο
Με ποιες τροφές να συνδυάζω ρύζι, πατάτες και ζυμαρικά για να μην αυξάνεται απότομα το σάκχαρο Πηγές Ιατρικού Αθηνών: Δεν ισχύουν οι φήμες
Πηγές Ιατρικού Αθηνών: Δεν ισχύουν οι φήμες Ιατρικό Αθηνών: Limit up εν μέσω φημών
Ιατρικό Αθηνών: Limit up εν μέσω φημών Ρύζι, πατάτες και ζυμαρικά: Ποιο είναι χειρότερο για το σάκχαρο;
Ρύζι, πατάτες και ζυμαρικά: Ποιο είναι χειρότερο για το σάκχαρο; ΕΟΠΥΥ: Στο 1,1 δισ. ευρώ έκλεισαν clawback - rebate φαρμάκων το 2025 - Επίσημος απολογισμός
ΕΟΠΥΥ: Στο 1,1 δισ. ευρώ έκλεισαν clawback - rebate φαρμάκων το 2025 - Επίσημος απολογισμός Συγκλονισμένοι οι υγειονομικοί από τον θάνατο 36χρονης γιατρού στη Μυτιλήνη
Συγκλονισμένοι οι υγειονομικοί από τον θάνατο 36χρονης γιατρού στη Μυτιλήνη Τι ζητούν οι Τεχνολόγοι Ιατρικών Εργαστηρίων
Τι ζητούν οι Τεχνολόγοι Ιατρικών Εργαστηρίων